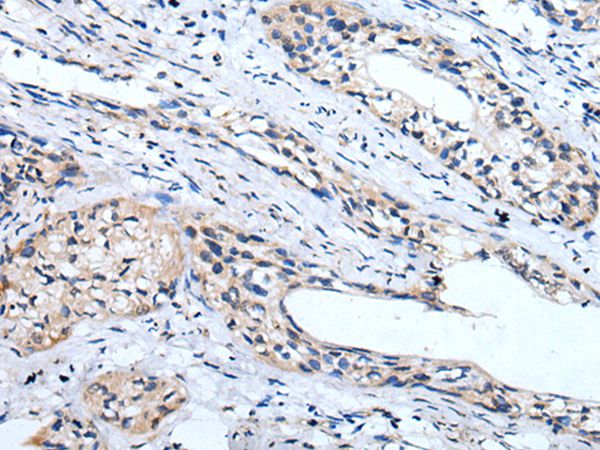

LINGO1 Antibody (Preservative Free)
LS-C815366
ApplicationsImmunoHistoChemistry, ImmunoHistoChemistry Paraffin
Product group Antibodies
TargetLINGO1
Overview
- SupplierLifeSpan BioSciences
- Product NameLINGO1 Antibody (Preservative Free)
- Delivery Days Customer14
- Application Supplier NoteApplications should be user optimized.
- ApplicationsImmunoHistoChemistry, ImmunoHistoChemistry Paraffin
- Applications SupplierIHC-P (1:2500 - 1:10000) Applications should be user optimized.
- CertificationResearch Use Only
- ClonalityPolyclonal
- ConjugateUnconjugated
- Estimated Purity...
- Gene ID84894
- Target nameLINGO1
- Target descriptionleucine rich repeat and Ig domain containing 1
- Target synonymsLERN1, LRRN6A, MRT64, UNQ201, leucine-rich repeat and immunoglobulin-like domain-containing nogo receptor-interacting protein 1, leucine rich repeat neuronal 6A, leucine-rich repeat and immunoglobulin domain-containing protein 1, leucine-rich repeat neuronal protein 1
- HostRabbit
- IsotypeIgG
- Storage Instruction-20°C or -80°C,2°C to 8°C
- UNSPSC12352203